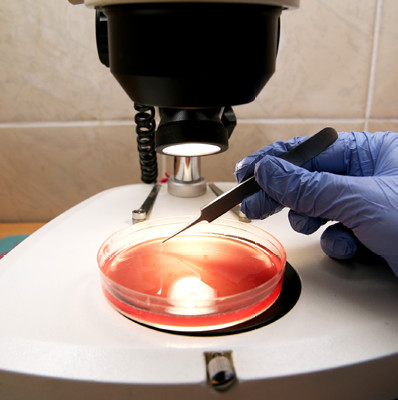

Санкт-Петербургский университетНаука
Тесты с высокой обоснованностью
Люди всегда хотели знать о себе больше: своих корнях, здоровье и возможных рисках. Сегодня специалисты лабораторной генетики помогают ученым и врачам искать ответы на многие вопросы. Важно их правильно задать, а ответы верно интерпретировать.

Вот почему таким специалистам лабораторной диагностики нужна базовая фундаментальная подготовка в области генетики. Ведь на основе их заключения врач-генетик ставит диагноз и выстраивает либо траекторию оказания медицинской помощи, либо тактику наблюдения и сопровождения пациента. Именно на основании заключения по результатам лабораторного исследования решаются такие судьбоносные вопросы, как планирование и рождение ребенка или полная перестройки образа жизни. В СПбГУ уже не одно десятилетие готовят высококлассных специалистов-генетиков, которые работают в ведущих медицинских научно-исследовательских институтах страны. Одна из них — Анна Андреевна Пендина, старший научный сотрудник СПбГУ (кафедра генетики и биотехнологии), биолог высшей квалификационной категории отдела геномной медицины имени В. С. Баранова Научно-исследовательского института акушерства, гинекологии и репродуктологии имени Д. О. Отта, кандидат биологических наук. Она занимается диагностическими исследованиями хромосомных патологий уже почти 30 лет и как никто знает, насколько наука продвинулась вперед в данном направлении и что сегодня генетика может рассказать человеку о нем самом с высокой точностью.

46 или 48?
В 1923 году прошлого столетия американский цитолог Теофилус Пейнтер опубликовал работу, в которой заявил, что у человека 48 хромосом. «Ошибка закралась из-за низкого качества препаратов, которые он анализировал. В науке очень с ложно опровергнуть то, что у же опубликовано в авторитетных журналах. Поэтому человечество пребывало в заблуждении относительно числа хромосом еще 30 лет, пока в 1950-х годах две группы ученых, изменив методику подготовки препаратов, не сошлись на том, что хромосом у человека 46», — рассказывает Анна Пендина. Чуть позднее французский врач-педиатр, генетик Жером Лежён пытался найти причину умственной отсталости у детей с синдромом Дауна. «На одной из конференций он услышал, что разработали методику получения метафазных хромосом из фибробластов кожи. Изучив образцы кожи у своих пациентов, Жером Лежён обнаружил, что у них 47 хромосом, а 21-я хромосома представлена тремя копиями вместо двух, — говорит Анна Пендина. — Это позволило понять роль наследственности в этиологии этого заболевания, что я вилось в определенном смысле революцией в науке и медицине. В последующем был сделан целый ряд открытий в области наследственных болезней и состояний».
Благодаря пониманию, что многие заболевания обусловлены изменением в системе хромосом, получила свое максимальное развитие медицинская генетика и клиническая цитогенетика в частности.
Тестирование или диагностика?
Сегодня, отправив в лабораторию биоматериал, человек может получить данные для поиска ответов почти на любой вопрос: от того, кем были его предки, до предрасположенности к определенным заболеваниям и даже наиболее подходящим видам спорта. Если у честь, что генетических тестов достаточно много, а генов у человека порядка 20 тысяч, то при наличии средств и интереса можно стать постоянным клиентом лабораторной службы. А нужно ли? Чтобы ответить на этот вопрос, предлагаем сначала разобраться в том, чем отличается генетическое тестирование от генетического диагностического исследования.
Это принципиально разные вещи. «В ходе тестирования мы определяем, какие особенности есть в генах у того или иного человека. Что это нам даст? По сути, не так и много. Дело в том, что любой сложный признак, например способность к обучению, определяется множеством генов. Есть комбинации более удачные, есть менее удачные. Однако невозможно утверждать, что человек с более удачной комбинацией будет учиться лучше, потому что мы не можем у честь, например, такую поведенческую особенность, как сила воли. Она играет большую роль в процессе обучения, — объясняет Анна Пендина. — Поэтому когда мы говорим о тестировании, то подразумеваем некую предсказательную модель, которая не очень точна. Эта неточность заложена в генетике человека, его природе».
По словам ученого, в определенный момент предсказательная генетика получила большую популярность, однако столь же быстро в научных к ругах интерес к ней существенно снизился. «Помимо того, что ген есть, он еще должен работать. А работать он может по-разному в разных условиях. У ребенка может не быть генетических предпосылок к легкому освоению музыкального инструмента. Однако благодаря трудолюбию и усердной работе ребенок способен продемонстрировать более высокие результаты, чем его одноклассник, обладающий изначально хорошими данными, но ленивый или не мотивированный», — отмечает Анна Пендина.
Совсем другое дело — диагностическое генетическое исследование. В ходе него специалисты ищут конкретную генетическую патологию и на основе полученных результатов ставят диагноз. В большинстве случаев необходимость проводить такой поиск возникает из-за наличия симптомов заболевания у самого пациента или его родственников. В последнем случае в лаборатории его либо подтвердят, либо опровергнут. «Самый яркий и понятный пример — синдром Дауна. Для выявления беременных женщин с высоким риском обнаружения у плодов синдрома Дауна или иной хромосомной патологии проводят скрининг, в который входит ультразвуковое исследование плода, биохимический анализ крови беременной или неинвазивный пренатальный тест (НИПТ). В ходе этих процедур можно определить данные, свидетельствующие о высокой или низкой вероятности выявления хромосомной болезни у плода. Если риск по результатам тестирования определяется как высокий, для подтверждения патологии требуется обязательное проведение диагностического генетического исследования», — поясняет Анна Пендина. В этом случае женщине предлагают пройти инвазивную пренатальную диагностику, в ходе которой делается забор ворсин хориона (наружная ворсинчатая оболочка зародыша у млекопитающих. — Прим. ред.), плаценты или амниотических вод. «В лаборатории на основании специальных технологических платформ анализируют генетический аппарат клеток плода. На основании чего и делается заключение о наличии или отсутствии изменения числа хромосом и их структуры. Этим отличается диагностика: она дает четкий и однозначный ответ на определенный вопрос, есть ли изменение числа и структуры хромосом, а также есть ли патогенные изменения в том или ином гене (например, если стоит задача диагностировать гемофилию, муковисцидоз и другие моногенные заболевания)», — говорит Анна Пендина.
До того как
Желание предотвратить рождение детей с тяжелыми наследственными заболеваниями привело к развитию пренатальной диагностики. Кстати, в нашей стране она зарождалась на берегах Невы в двух соседствующих учреждениях — в НИИ имени Д. О. Отта на базе отдела геномной медицины (ранее — лаборатория пренатальной диагностики наследственных и врожденных болезней. — Прим. ред.) и в Санкт-Петербургском университете на базе кафедры генетики и биотехнологии. Костяк коллектива отдела геномной медицины составляют выпускники Университета, а сам отдел в настоящее время носит имя члена-корреспондента РАН Владислава Сергеевича Баранова, который руководил им более 30 лет и также являлся профессором СПбГУ.
Сегодня технологии клинической лабораторной генетики позволяют не только с точностью установить, имеется ли генетическая патология у плода, но и помочь снизить риск рождения больного ребенка. Для этого разработаны и действуют программы преконцепционного генетического тестирования супружеских пар. Почему возникла в них необходимость? «В популяции достаточно много индивидов, которые являются носителями различных хромосомных аномалий и рецессивных патогенных вариантов генов. Это никак не влияет на их фенотип (совокупность всех внешних и внутренних признаков организма. — Прим. ред.), но повышает риск тяжелых патологий у потомства, — объясняет Анна Пендина. — Половые клетки, которые образуются в организме таких пациентов, генетически не сбалансированы. Если они участвуют в оплодотворении, формируется эмбрион с генетической патологией. Если она грубая, что бывает часто, то эмбрион погибает на до- или постимплантационных стадиях развития, что приводит к бесплодию или неразвивающейся беременности. Причина может крыться в носительстве определенного генетического изменения как у супруга, так и супруги. Вот почему диагностику должны проходить оба будущих родителя, даже если они сами совершенно здоровы. Только врачи-генетики в тандеме с лабораторными специалистами могут выяснить, есть ли у человека какие-то генетические особенности, которые могут предрасполагать к бесплодию, невынашиванию или рождению ребенка с наследственным заболеванием. Это очень важно».
Пройти преконцепционное генетическое исследование могут и пары, которые только планируют беременность и не имеют неудачного опыта на этом пути и жалоб. В этом случае, по мнению Анны Пендиной, начать стоит с консультации врача — клинического генетика. Именно он задаст те вопросы, которые человек перед собой сам поставить не может. Исходя из полученной от пары информации, врач рекомендует ряд обследований, а затем интерпретирует их и делает заключение, нуждается ли пара в индивидуальной маршрутизации на пути рождения ребенка, а если да, то какой именно. «Очень важна консультация именно высококвалифицированного врача-генетика, обладающего большим объемом специальных знаний. Опираясь на них, он назначает лабораторные исследования, каждое из которых направлено на выявление чего-то конкретного и важного именно для данной пары», — подчеркивает Анна Пендина.

Не навреди
Этот же принцип, по ее словам, должен применяться к любым генетическим исследованиям. Они должны быть назначены, проведены и интерпретированы высококлассными специалистами. Только так — и точка. «Помимо того, что результаты должны быть верно интерпретированы и корректно донесены до пациента, должна быть соблюдена также врачебная этика. Иногда медицинским специалистам приходится сообщать новости, которые ставят на кон многое в жизни человека, даже все дальнейшие планы, — приводит пример Анна Пендина. — Есть генетически обусловленные заболевания, которые имеют позднюю манифестацию. Например, с возраста 40–50 лет может развиваться тяжелое прогрессирующее состояние, обусловленное психическим и когнитивным нарушением. Жил себе человек и не тужил, и вдруг ему сообщают такую новость. Как ему жить следующие 20–25 лет? Создавать ли семью, сообщать ли супругу. Специалист знает, как построить беседу, кому такая информация может быть сообщена, а главное, что он способен корректно и научно обоснованно ответить на вопросы пациента».
Для многих неочевидна роль специалиста, который проводит исследование в лаборатории. Однако он является не менее значимой фигурой в процессе поиска ответов для постановки диагноза. «Специалисты лабораторной генетики не просто понимают и выстраивают сам процесс проведения исследования биоматериала. Они умеют правильно анализировать результат. Это очень важно. На них лежит большая ответственность, ведь на основании того, как они проведут анализ и как сформулируют заключение, врач будет ставить диагноз, который может повлиять на всю жизнь пациента», — подчеркивает Анна Пендина.
В СПбГУ это прекрасно понимают. Здесь, на базе кафедры генетики и биотехнологии, сформирована школа подготовки таких специалистов. В образовательные программы различных уровней заложены курсы, в рамках которых происходит не только необходимая фундаментальная теоретическая подготовка, но и освоение практических навыков. «В итоге мы выпускаем классных специалистов лабораторного дела, которые не просто хорошо понимают и знают весь процесс работы, но и осознают меру ответственности за свои заключения», — отмечает Анна Пендина.

Осмысленный подход
Не стоит относиться легкомысленно к генетическим тестам, исследованиям и самим потенциальным пациентам. Личный интерес, а также забота о своем здоровье и здоровье потомства должны оставаться в рациональных рамках и иметь конкретную цель. Это не те анализы, которые стоит назначать самим себе, а потом искать пояснения в интернете. Как уже рассказала Анна Пендина, необходимо четко понимать, что вы ищете, для чего и как полученные сведения могут на вас повлиять. Ведь сама по себе информация о том, что у человека имеются патогенные варианты в каком-то гене или есть предрасположенность к какой-то болезни без привязки к симптомам, может быть бесполезной или даже оказать отрицательный эффект. Человек начнет тревожиться, ожидать наступления болезни, кодируя себя на негативный сценарий. «Мы все генотипически очень разные и сложные. Само наличие патогенного варианта в гене не говорит, что человек обязательно заболеет. Болезнь может не манифестировать вообще или проявиться в легкой, стертой форме, так как в организме человека работают компенсаторные механизмы. Вот почему искать что-то без наличия клинической картины или отягощенного семейного анамнеза не всегда имеет практический смысл», — поясняет Анна Пендина.
Правильнее стараться вести здоровый образ жизни, а при наличии вопросов начать с консультации у врача-генетика.
Хочешь стать одним из более 100 000 пользователей, кто регулярно использует kiozk для получения новых знаний?
Не упусти главного с нашим telegram-каналом: https://kiozk.ru/s/voyrl
